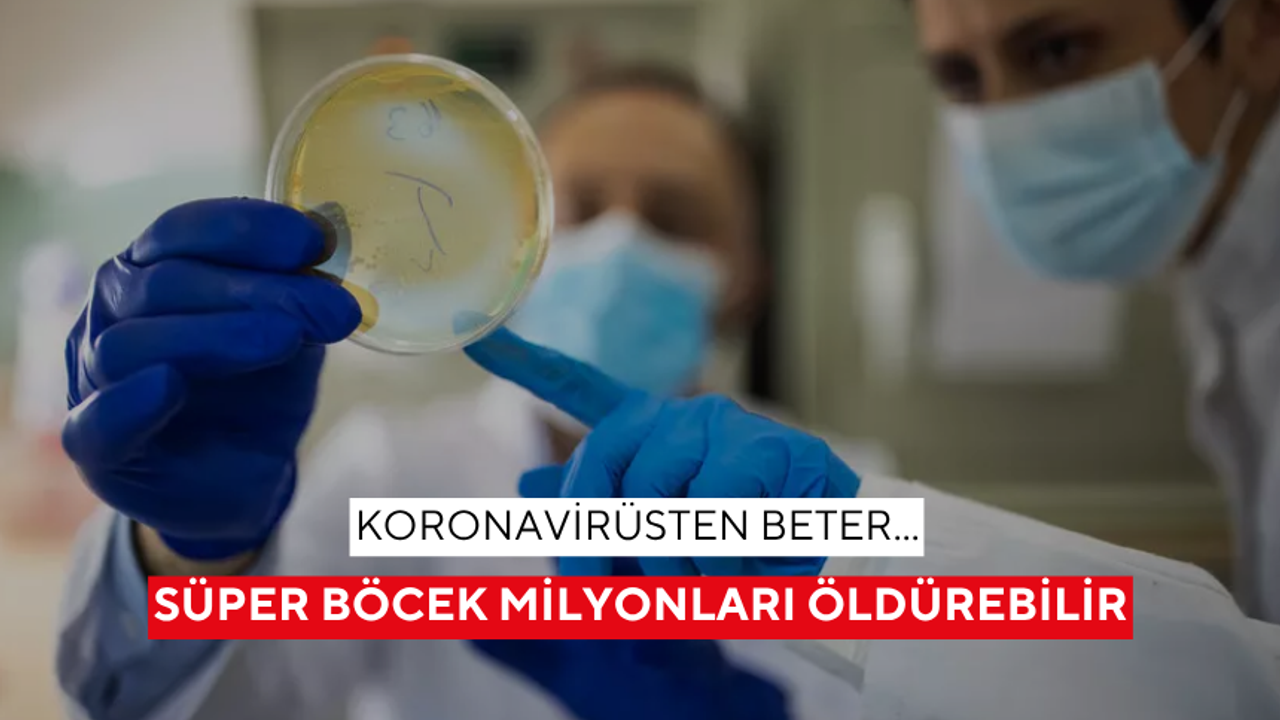

Dünya yeni bir kıskacın eşiğinde. 'Süper böcekler' hayatlarımızda aynı koronavirüs pandemisi gibi köklü değişiklikler yaratabilir. Bilim insanlarının araştırmalarına göre milyonlarca insan şimdiden ölüm riski altında...

MİLYONLARCA İNSAN TEHDİT ALTINDA...
NTV'nin The Guardian gazetesinden çevirdiği habere göre, 'Süper böcekler', 2050 yılına kadar milyonlarca insanın ölümüne yol açabilir ve küresel ekonomiye yaklaşık 2 trilyon dolara mal olabilir. İngiltere hükümeti tarafından finanse edilen bir çalışma, ortak bir eylem olmadan, antimikrobiyal direnç (AMR) oranlarının yükselişinin, önümüzdeki çeyrek yüzyılda, küresel olarak yıllık 1.7 milyon dolar gayrısafi yurt içi hasıla (GSYH) kaybına yol açacağını gösteriyor.

'SÜPER BÖCEKLER' ANTİBİYOTİKLERE DİRENÇLİ
Sağlık Ölçümleri ve Değerlendirme Enstitüsü'ne (IHME) göre, AMR'den kaynaklanan ölümlerin 2050 yılına kadar yüzde 60 oranında artması bekleniyor. Sadece ABD'de 1,34 milyon ve İngiltere'de 184 bin kişinin her yıl antibiyotiklere dirençli böcekler nedeniyle öleceği tahmin edilirken, ilaca dirençli bakteriler nedeniyle ciddi şekilde hastalananların sayısının da artması bekleniyor.
TEDAVİSİ İKİ KAT DAHA PAHALI
Süper böcekler hastaneye yatış sayısını arttırırken, daha uzun ve daha yoğun hastane yatışlarına, daha maliyetli ikinci basamak tedavilere ve daha karmaşık bakıma yol açıyor. Bu da dirençli enfeksiyonların tedavisinin antibiyotiklerin etkili olduğu enfeksiyonlara kıyasla yaklaşık iki kat daha pahalı olduğu anlamına geliyor.

"EN BAŞARILI ÜLKELER BİLE RİSK ALTINDA"
Araştırmanın başyazarı ve Küresel Kalkınma Merkezi'nde politika uzmanı olan Anthony McDonnell, AMR oranlarını kontrol altında tutma konusunda başarılı olan ülkelerin bile rehavete kapılmayı göze alamayacağını söyledi. McDonnell, AMR programları yardım kesintilerinden korunmadığı sürece, dünya genelinde direnç oranlarının muhtemelen en kötü etkilenen ülkelere paralel bir oranda artacağını belirtti.
McDonnell, şunları ekledi: "Bu durum, G7 ülkeleri de dâhil olmak üzere dünya genelinde milyonlarca insanın daha ölmesine yol açacaktır. Bakteriyel enfeksiyonların tedavisine şimdi yatırım yapmak hayat kurtaracak ve uzun vadede milyarlarca dolarlık ekonomik getiri sağlayacaktır."

EKONOMİK DARBE: İŞ GÜCÜ AZALACAK, KAYIP 2 TRİLYON DOLARA DAYANABİLİR
Araştırma, 122 ülke için antibiyotik direncinin ekonomik ve sağlık yükünü hesaplamış ve bu en kötümser senaryoda, 2050 yılına kadar Çin'de GSYİH kayıplarının yılda 722 milyar doların biraz altına, ABD'de 295,7 milyar dolara, AB'de 187 milyar dolara, Japonya'da 65,7 milyar dolara ve İngiltere'de 58,6 milyar dolara ulaşabileceğini tahmin ediyor.
Araştırmaya göre daha yüksek dirençli böcek oranları da İngiltere, AB ve ABD'deki iş gücünü sırasıyla yüzde 0,8, yüzde 0,6 ve yüzde 0,4 oranında azaltacak.
Ancak ülkeler süper böceklerle mücadeleye daha fazla yatırım yaparsa, yani yeni antibiyotiklere erişimi ve bu enfeksiyonların yüksek kalitede tedavisini arttırırsa, 2050 yılına kadar ABD ekonomisi yılda 156,2 milyar dolar, İngiltere ise 12 milyar dolar büyüyecek.